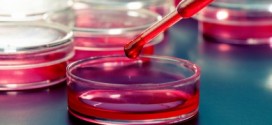
Simple blood test could detect cancer, Study

Behold the oarfish, the world’s longest bony fish. The beasts typically live hundreds of feet below the ocean surface are thus are rarely seen. Since 2002, however, a few videos (like the one below) have surfaced and given scientists important clues about the animals.
Read More »News
Detroit mob attack : Police Arrest Fifth Suspect in Steven Utash Beating
Almost one week has passed since the brutal attack of a driver in Detroit who stopped to help a little boy he had accidentally just hit with his car. In a bankrupt city with too few police, authorities are working fast to bring justice. Three people have been charged with assault – two adults and one teenager. A second teenager …
Read More »Pennsylvania school stabbing : 20 injured, suspect in police custody
As many as 20 people were injured after a stabbing spree inside Franklin Regional High School in Murrysville, Pa., at the start of the school day, emergency management officials said. Westmoreland County emergency management spokesman Dan Stevens said no fatalities were reported.
Read More »Marine guard shot to death by colleague at North Carolina base
One Marine was shot to death by a colleague at Camp Lejeune in North Carolina on Tuesday afternoon. The incident happened at around 5.30 pm on Tuesday. The Marine who fired the shot from his M4 rifle was detained and is to be questioned by the Naval Criminal Investigative Services, according to reports of the Washington Post.
Read More »Simple blood test could detect cancer, Study
A blood sample could one day be enough to diagnose many types of solid cancers, or to monitor the amount of cancer in a patient’s body and responses to treatment. Previous versions of the approach, which relies on monitoring levels of tumor DNA circulating in the blood, have required cumbersome and time-consuming steps to customize it to each patient or …
Read More »Earnhardt Jr. Out Of Texas Race After Fiery Crash
The Duck Commander 500 was postponed until Monday. The first ten laps of the race were run under caution and once the race went green it took only a few laps before one car found it’s way off the track. Dale Earnhardt Jr. said in a interview that he made a mistake and drove his No. 88 National Guard Chevrolet …
Read More »James Argent says his new book will show Lydia Bright he’s ‘genuinely sorry’
The Essex boy became a household name as one of the original cast members of the hit ITV2 series, but he paid the price of fame when rumours of cheating finished his four year relationship with his “first love”. With Lydia no longer appearing in the series, Arg admitted to This Morning’s Phillip and Holly that he has had no …
Read More »Spinal cord stimulator : Research Helps Paralyzed Men Move
Four young men who have been paralysed for years achieved groundbreaking progress – moving their legs – as a result of epidural electrical stimulation of the spinal cord, an international team of life scientists at the University of Louisville, UCLA and the Pavlov Institute of Physiology reported in the medical journal Brain.
Read More »Trucker Named As 1990 Murder Suspect
Two murdered teenagers. Two Wisconsin cold cases. And now, many years later, two breaks that finally may lead to charges. Investigators in Racine and Fond du Lac counties announced separately over the weekend that they have new developments in cold cases from the 1990s — the killings of 14-year-old Amber Gail Creek and 18-year-old Berit Beck — and news conferences …
Read More »Niijima Island : New volcanic swallows neighbor
Niijima is Japan’s newest island located in the Philippine Sea that has consistently grown in size since its inception in November. A NASA satellite image from March 30 found that Niijima merged with nearby island Nishino-shima.
Read More »Paula Deen Restaurant Closed, without telling employees : Reports
After 10 years, beleaguered ex-Food Network star Paula Deen and her team have suddenly shuttered Uncle Bubba’s Seafood & Oyster House in Savannah, Georgia. TMZ reports that employees showed up to work this morning only to find the restaurant closed and its appliances being removed. On the Uncle Bubba’s Facebook page the company simply writes: “Thank you for 10 great …
Read More » Canada Journal – News of the World Articles and videos to bring you the biggest Canadian news stories from across the country every day
Canada Journal – News of the World Articles and videos to bring you the biggest Canadian news stories from across the country every day